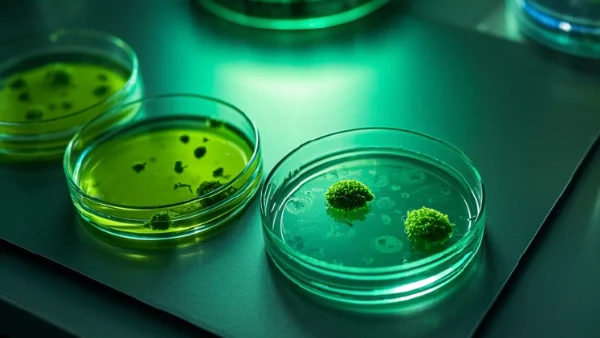
细菌培养与药敏试验:揭开抗生素疗法的神秘面纱

01 细菌培养原理:看不见的战场
生活里,其实很少有人真正见过什么叫“细菌培养”。想象一下,当身体出现不明原因的感染症状时,医生偶尔会建议“先培养下看看”。这背后并不是神秘实验,简单来说,就是把病人体内的细菌“请出来”,放到像营养餐一样的培养基上,用适合他们生长的条件,看看它们“长成什么样”。这个过程中,细菌以肉眼看不见的形式迅速繁殖,像在赛跑一样比拼速度。
培养的目的,其实就是把细菌的本来面目暴露出来——方便后续分析、识别和进一步判断。如果只凭经验用药,可能会用错药。而通过培养,医生就能有的放矢去对付具体的细菌。
02 培养基的种类与选择(如何为细菌“点菜单”?)
- 1. 巴氏培养基: 这是最常用的基本款,适合大部分常见细菌。不过,有些“挑食”的细菌就不太适合在这里生存。
- 2. 血琼脂培养基: 如果医生怀疑患者体内有需要特殊“待遇”的致病菌,会选择营养更丰富的血琼脂,让那些挑剔的细菌也能安心长大。
- 3. 麦康凯培养基: 专为肠道细菌设计,可以帮助鉴别大肠杆菌和非大肠杆菌性细菌。
有些病原菌像喉咙炎导致的溶血性链球菌,需要血琼脂才能看清楚其“肆虐”的特征,而泌尿系统感染常规会用麦康凯培养基,直接识别肠道相关菌。
03 细菌培养的步骤(实验室内的流水线作业)
| 步骤 | 关键操作 | 常见问题 |
|---|---|---|
| 样本采集 | 选用无菌采集器,比如咽拭子、尿液容器 | 样本易被体表微生物污染 |
| 接种培养基 | 将样品轻柔涂在固体/液体培养基表面 | 操作不规范会导致假阳性 |
| 培养 | 放进恒温箱(通常35-37℃),细菌适宜的温度湿度 | 温度过高/低会影响细菌生长 |
| 观察与分析 | 每天定时观察菌落形态、颜色、量等特征 | 部分慢性菌种培养需更长时间 |
有位48岁的女性,因反复发热被采集了血液样本送检。24小时后,实验员就从培养基上观察到细小的黄色菌落,进一步的分析为葡萄球菌,为她后续治疗指明了方向。这个例子说明规范操作能大大提高诊断准确性。
04 药敏试验:筛选最合适的“武器”
细菌培养出来之后,真正考验还在后面——药敏试验。很多人肯定有过这样的疑问:为什么吃抗生素没见效果?其实不同细菌对某些抗生素“天生无感”,如果选错了药,不但疗效差,还可能无形中给细菌“打上甲壳”,让它们变得越来越顽固,这就是“耐药性”的来历。
05 药敏试验的常用方法与场景
不同方法各有优缺点,就像找“最合胃口的菜谱”一样,下面这三种方法在临床最常见。
| 方法 | 优点 | 局限 | 适用场景 |
|---|---|---|---|
| 纸片扩散法(K-B法) | 操作简便、费用较低 | 不能准确测出最小抑菌浓度 | 一般感染初筛 |
| 琼脂稀释法 | 能测出最小抑菌浓度(MIC值) | 技术要求高,耗时长 | 慢性或复发性感染 |
| 自动化分析仪 | 速度快、信息全面 | 费用较高,灵活性差 | 大医院常规使用 |
比如,一名22岁男大学生因肺部感染住院,通过自动化分析仪仅需半天就获得了详细的药敏报告。这大大缩短了确诊时间,让医生能尽早选对药物,避免了延误治疗带来的风险。
06 检查结果怎么用?解读与应用小技巧
拿到检验报告单后,面对一排复杂的抗生素名称和“S/I/R”标记,患者和家属常常一头雾水。其实,S(敏感)表示细菌容易被药物杀灭,I(中介)意味着效果一般,R(耐药)说明这类药物很难奏效。医生会结合感染部位、患者年龄、肝肾功能等综合因素来选药。
| 报告标记 | 含义 | 后续建议 |
|---|---|---|
| S(敏感) | 细菌对该药物易被杀灭 | 优先选用,副作用较小 |
| I(中介) | 药物效果一般 | 可在无他药时短期应用 |
| R(耐药) | 细菌难以被杀灭 | 一般避免使用 |
需要提醒:结果的具体应用需由临床医生综合判断,千万别自己对照结果乱用药物。药敏试验可以帮助选药,但个人体质、病情轻重等也会影响最终效果。
小结:标准化检验流程与及时解读,有助于实现治疗个体化,避免滥用抗生素带来的健康风险。
07 正确预防与就医:让细菌无机可乘
说起来,预防感染最有效的办法并不神秘,反而很基础。例如,在流感季洗手、合理饮食,都能帮助减少细菌感染的机会。对经常出现呼吸道反复感染或者尿路感染的人,适当增强抵抗力很重要,下面是几个实用建议:
- 鲜蔬水果类: 富含维C,有助提升免疫水平。建议:每日适量搭配,比如3种蔬菜和2种水果。
- 牛奶及坚果类: 富有优质蛋白和微量元素,对恢复与修复组织有益。建议:早餐或加餐时适量摄入。
- 全谷杂粮: 钙、锌、铁等营养成分丰富,有助维持肠道菌群平衡。建议:主食部分一半改为全谷类。
医院选择上,建议首选有临床微生物实验室的正规医疗机构。接受培养和药敏检测前可以提前咨询相关流程,带好以往就医记录,方便医生全面判断。
参考文献
- Jorgensen, J. H., & Ferraro, M. J. (2009). Antimicrobial susceptibility testing: a review of general principles and contemporary practices. Clinical Infectious Diseases, 49(11), 1749-1755. https://doi.org/10.1086/647952
- Baron, E. J., & Miller, J. M. (2018). Bacterial and fungal infections. In Henry's Clinical Diagnosis and Management by Laboratory Methods (23rd ed., pp. 1004-1026). Elsevier.
- Balouiri, M., Sadiki, M., & Ibnsouda, S. K. (2016). Methods for in vitro evaluating antimicrobial activity: A review. Journal of Pharmaceutical Analysis, 6(2), 71-79. https://doi.org/10.1016/j.jpha.2015.11.005